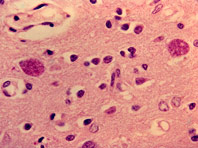

Пейте на здоровье: названы полезные свойства вина
Вино в небольших количествах полезно для организма. Любите порой осушить бокал вина, знаете разницу между базовыми нотами Каберне и Пино Нуар или просто любите насладиться бокалом красного после долгого трудового дня? Но когда вокруг столько разговоров о ЗОЖ и вреде алкоголя, расслабляющие напитки как-то уходят на второй план. Эксперты решили рассказать, какова же польза и…